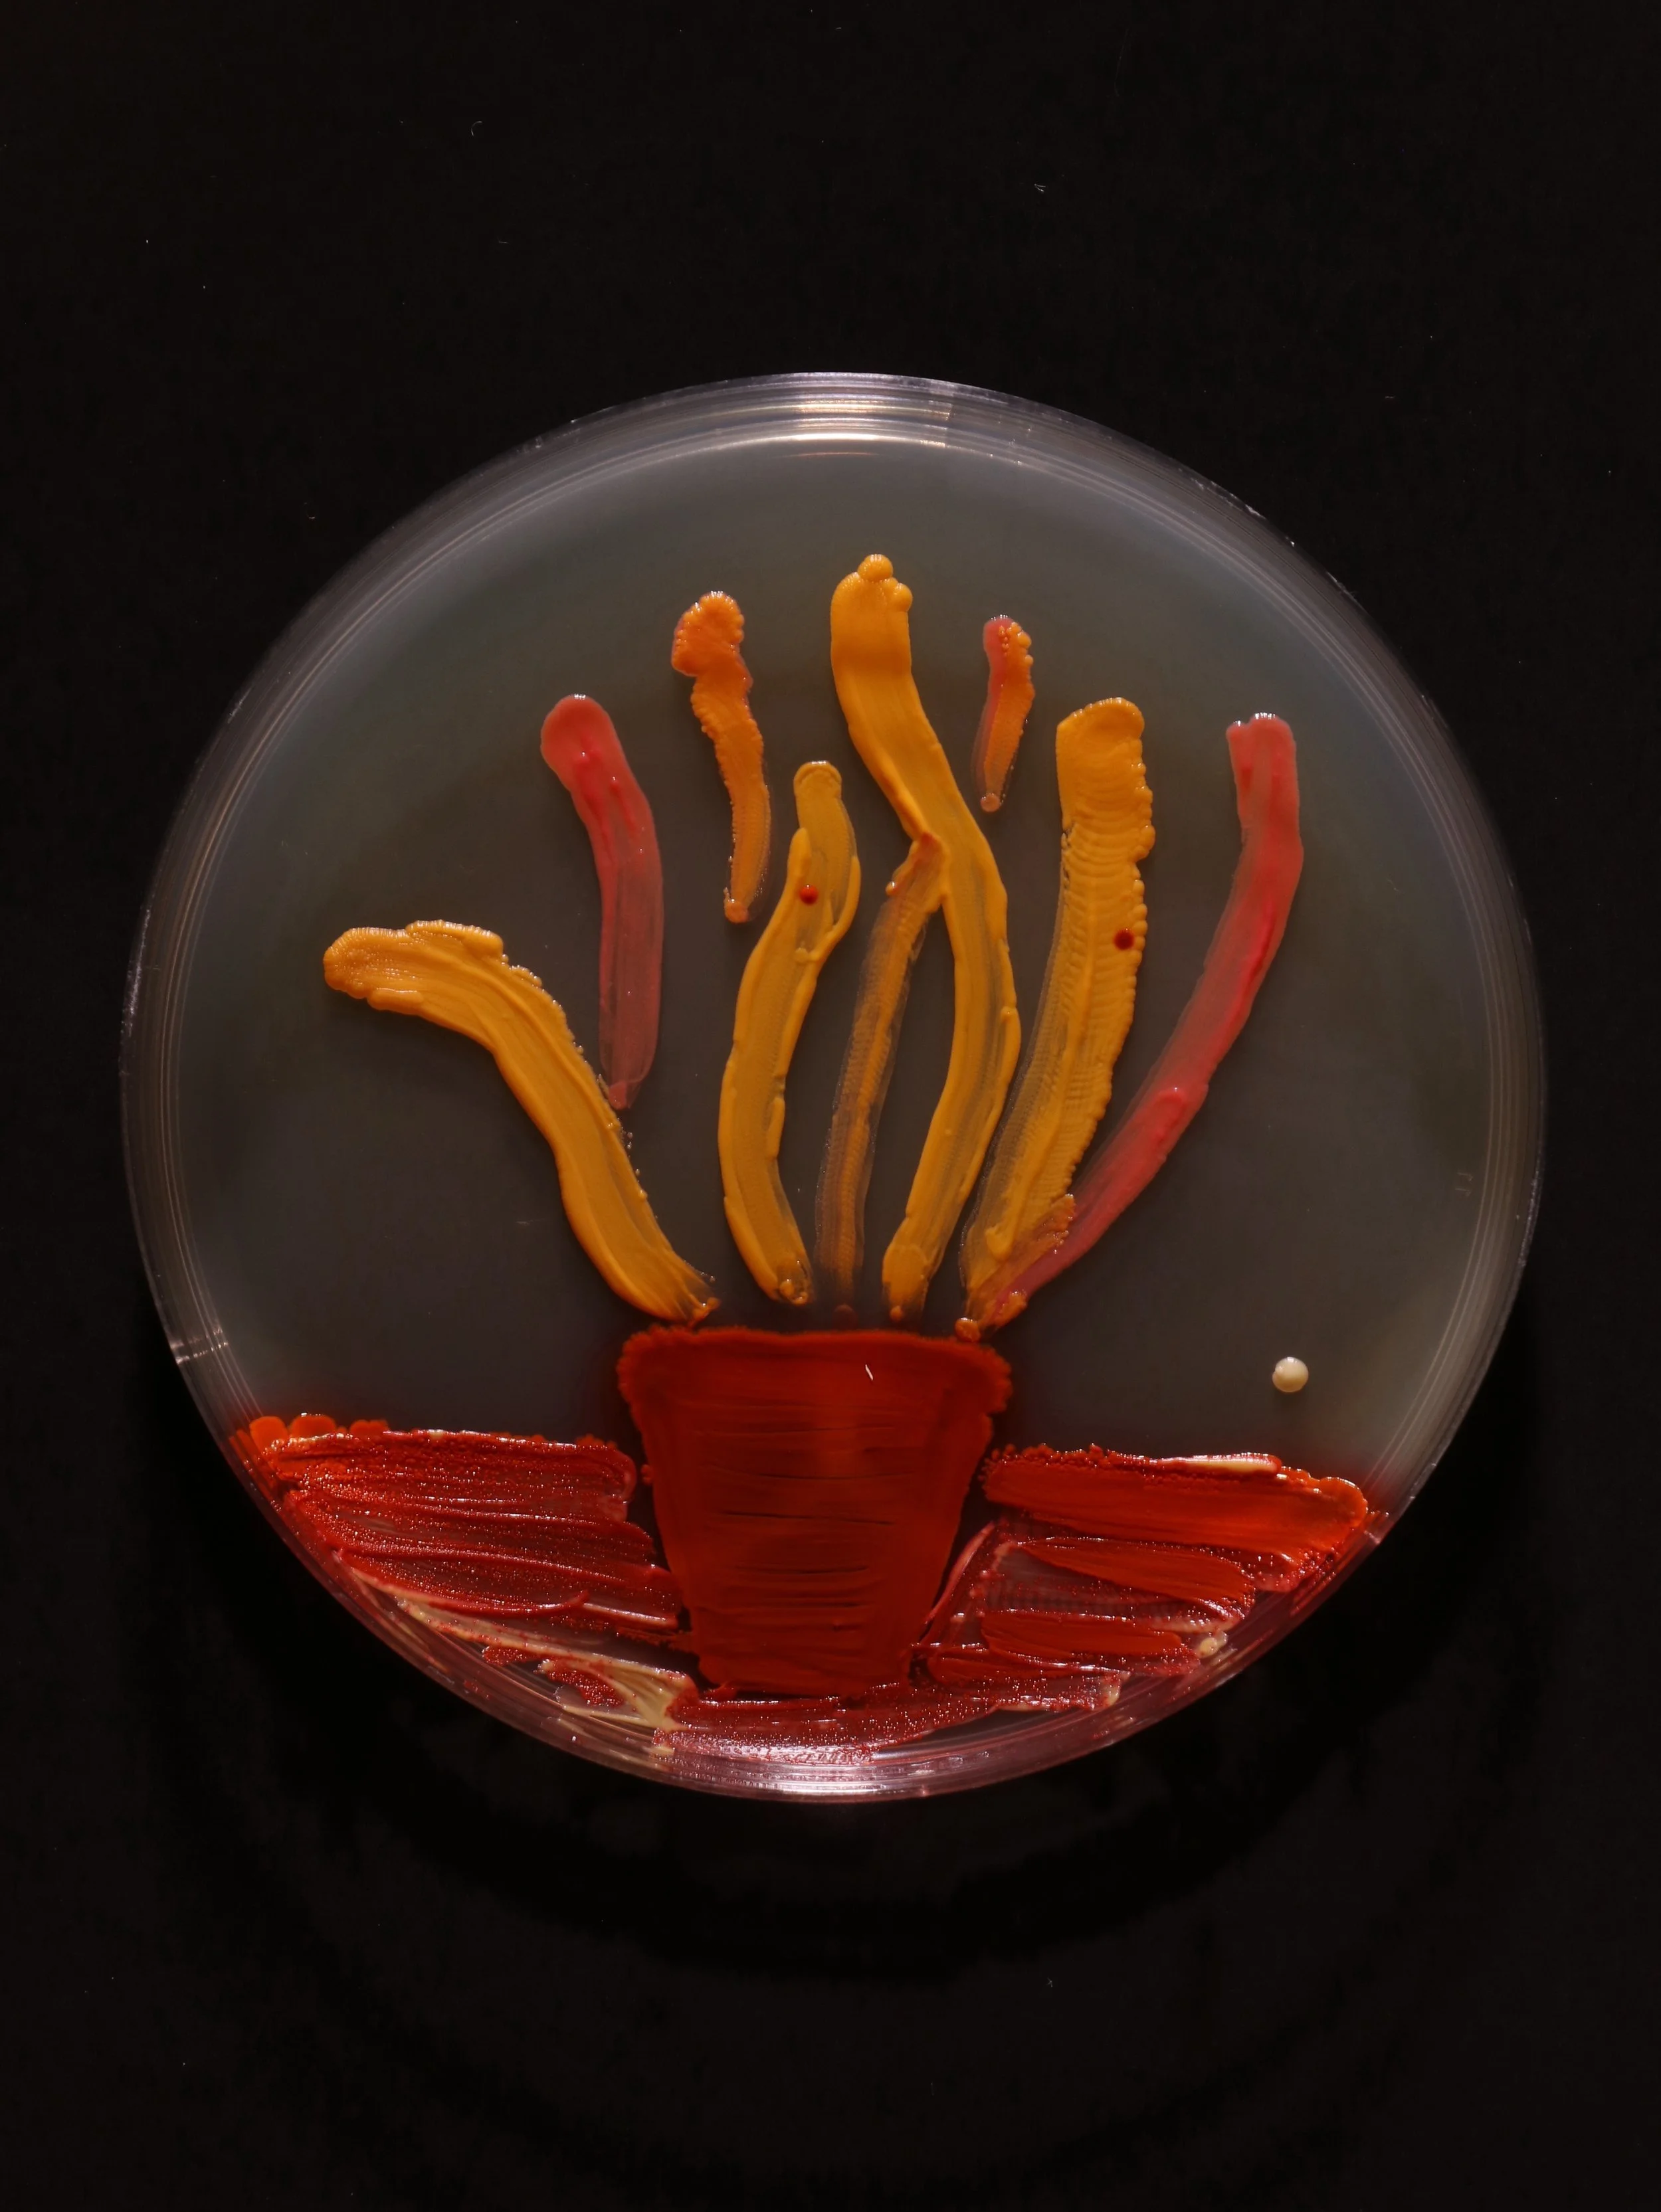

The two bacteria drawings in this series are made using specific bacterias which have bright colors. Ajaya used these bacteria to draw in petri dishes and make representational drawings
Untitled (Flower)
100 mm (diameter) x 15 mm
Medium: agar, bacteria,
2023
Untitled (Snake Plant)
100 mm (diameter) x 15 mm
Medium: agar, bacteria, black drawing ink
2023